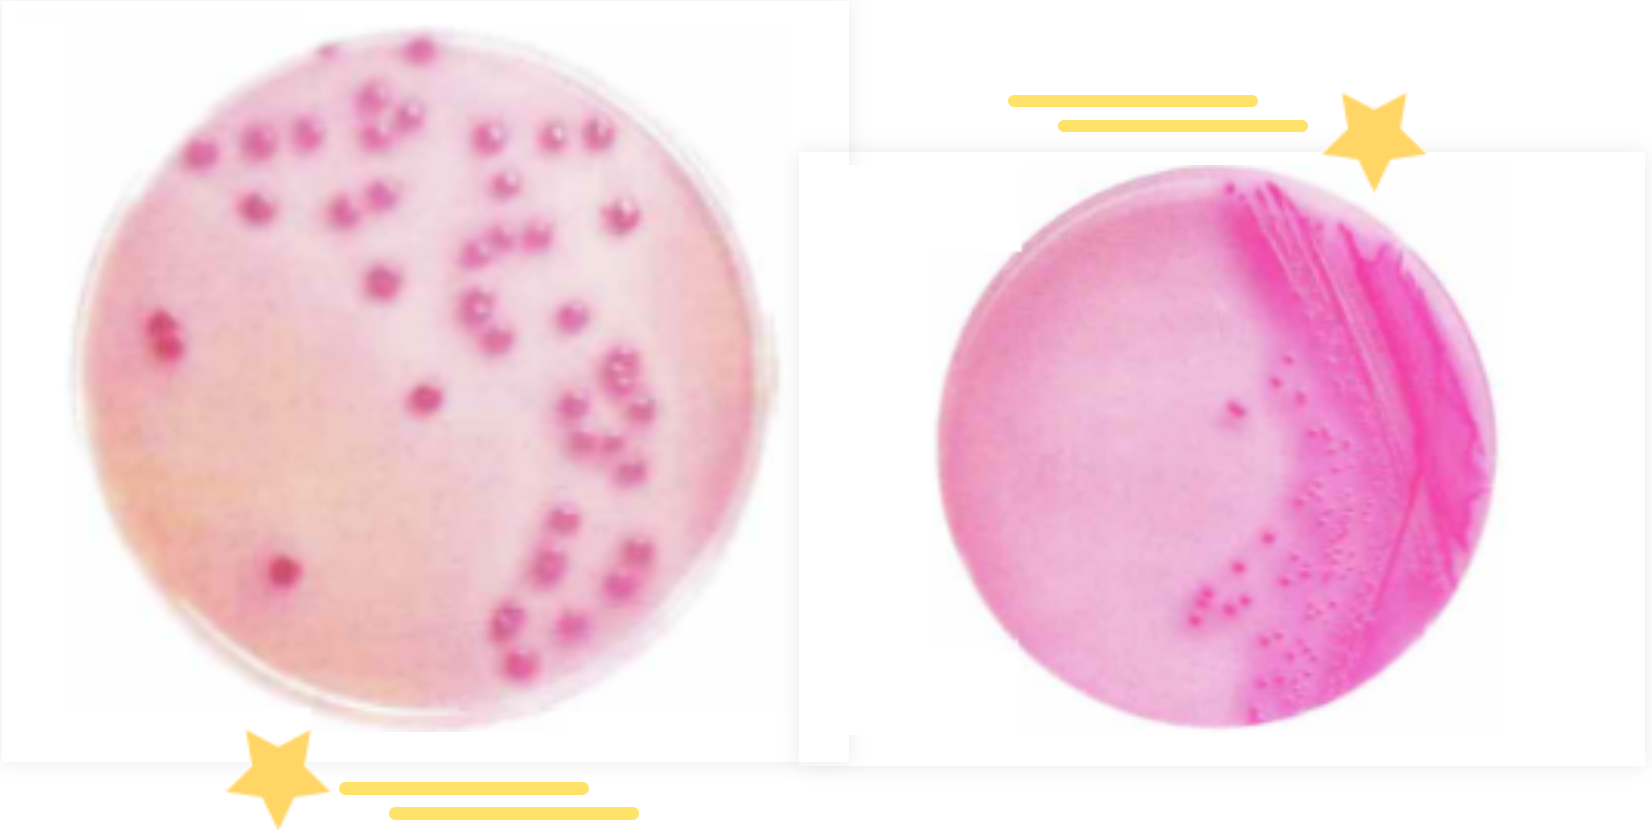

食品中大肠菌群&金黄色葡萄球菌检测时常见的问题及原因解析
发布时间:2025-05-09 浏览次数:2945
01 大肠菌群
大肠菌群:是指一群能发酵乳糖、产酸、产气、需氧和兼性厌氧的革兰氏无芽孢杆菌 。该菌主要来源于人畜粪便,大肠菌群是评价食品卫生质量的重要指标之一。
目前,食品中大肠菌群检测方法国内主要采用 GB 4789.3-2016 和 GB/T4789.3-2003 标准、进出口企业采用的ISO方法或者客户提供的检测方法等。
目前国内的GB/T 4789.3-2003标准:采用三步法,即:乳糖发酵试验、分离培养和证实试验;而 GB 4789.3-2016 标准,采用两步法,即:发酵推测实验、证实实验。
检测该菌的方法主要有MPN法,平板计数法。MPN法中主要用到的是LST、BGLB、EC肉汤等;平板计数法主要是VRBA、去氧胆酸盐等。
01 在检测该菌时易出现的问题:
1、 LST、BGLB、EC等在灭菌时小倒管中气泡排不尽;
2、灭菌后培养基颜色异常;
3、灭菌后培养基出现沉淀;
4、培养后气泡不易观察;
5、VRBA、去氧胆酸盐平板上菌落特征不易辨认;
6、平板法培养基不凝固等。
02 原因分析:
1、在分装LST、BGLB、EC时,小倒管中有水柱;此外,高压灭菌时,需急排气,灭菌后迅速冷却。
2、在制备过程中过度加热;水质不佳(GB/T 27405-2008标准中5.4.2.5中强调实验室培养基、试剂及稀释剂配制用水应经蒸馏、去离子或反渗透处理,电阻率在25℃时应≥300 000 Ω.cm,建议每周检测一次);或者脱水培养基质量差。
3、在发酵试验工作中,经常可以看到在发酵倒管内极微少的气泡(有时比小米粒还小),有时可以遇到在初发酵时产酸或沿管壁有缓缓上浮的小气泡。实验表明,大肠菌群的产气量,多者可以使发酵倒管全部充满气体,少者可以产生比小米粒还小的气泡。如果对产酸但未产气的乳糖发酵如有疑问时,观察气泡时,可以用手轻轻打动试管,如有气泡沿管壁上浮,即应考虑可能有气体产生,然后作进一步试验。
4、熟悉大肠菌群在上述平板上的特征,必要可做一些阳性的对照。有些食物残渣会影响观察结果,这样需要我们在培养前仔细观察平板的状态,大的食物残渣可以做一些标记。
5、一般是在制备过程中称量不正确、或者培养基制备后未充分混匀。
02 金黄色葡萄球菌
金黄色葡萄球菌:是人类化脓感染中最常见的病原菌,可引起局部化脓感染,也可引起肺炎、败血症等,其毒性的强弱取决于产生的毒素和侵袭性酶,例溶血素酶、杀白细胞素、血浆凝固酶、脱氧核糖核酸酶。
01 限量标准:
我国国家卫生和计划生育委员会于 2021年9月发布了《食品安全国家标准 食品中致病菌限量》(GB 29921-2021),在国标中制定了金黄色葡萄球菌的限量标准,规定肉制品、粮食制品、即食豆制品、即食果蔬、即食调味品等7大类食品中,同批次采集 5 份样品,每份样品中的金黄色葡萄球菌浓度均不得超出 1000 CFU/g,仅允许其中1份样品在 100~1000 CFU/g之间。
新版标准中还增加了乳制品中金黄色葡萄球菌的限量要求。

02 检测方法:
目前,国内检测食品中金黄色葡萄球菌依据国家标准《食品微生物学检验 金黄色葡萄球菌检验》(GB4789.10-2016)检测该菌的方法主要有MPN法,平板计数法;主要用到的是7.5%氯化钠肉汤、Baird-Parker平板,血平板等。
B-P琼脂上金黄色葡萄球菌有黑色的菌落中心,周围有半透明的卵磷脂沉淀环。金黄色葡萄球菌在B-P上的菌落特征如下图:

03 检样中常见的问题:
1、7.5%氯化钠肉汤中呈混浊生长,怎么判断;
2、平板的状态:透明、有絮状物。
3、凝固酶实验的观察。
04 原因分析:
1、由于食品颗粒的影响,这步不容易观察,最好是进行下一步验证。
2、不同的厂家的培养基平板制好后的状态有所不同,主要取决于亚碲酸钾卵黄增菌液的不同。根据各厂家的培养基说明制定相应的实验室SOP.
3、在添加亚碲酸钾卵黄增菌液时,温度的掌握,不宜太高,过高易使卵黄变性,也不应太低,太低琼脂易凝固。
4、将金黄色葡萄球菌接种到兔血浆上后,每半小时观察一次,观察凝固时,将血浆轻轻倾斜或慢慢倒置,如有流动,既证明没有凝固。不同厂家的冻兔血浆,可能会有差异,仔细阅读作业指导书。
说明:转载仅为分享目的,部分文章图片因转载众多无法确认原始作者的,仅标明转载来源;版权归原作者所有,如有问题,请联系小编删除,谢谢!
